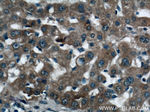
KHK Antibody in Immunohistochemistry (Paraffin) (IHC (P))

Search
Proteintech
KHK Polyclonal Antibody
{{$productOrderCtrl.translations['antibody.pdp.commerceCard.promotion.promotions']}}
{{$productOrderCtrl.translations['antibody.pdp.commerceCard.promotion.viewpromo']}}
{{$productOrderCtrl.translations['antibody.pdp.commerceCard.promotion.promocode']}}: {{promo.promoCode}} {{promo.promoTitle}} {{promo.promoDescription}}. {{$productOrderCtrl.translations['antibody.pdp.commerceCard.promotion.learnmore']}}
产品信息
15681-1-AP
种属反应
已发表种属
宿主/亚型
分类
类型
抗原
偶联物
形式
浓度
规格
纯化类型
保存液
内含物
保存条件
运输条件
产品详细信息
Immunogen sequence: MEEKQILCV GLVVLDVISL VDKYPKEDSE IRCLSQRWQR GGNASNSCTI LSLLGAPCAF MGSMAPGHVA DFVLDDLRRY SVDLRYTVFQ TTGSVPIATV IINEASGSRT ILYYDRSLPD VSATDFEKVD LTQFKWIHIE GRNASEQVKM LQRIDAHNTR QPPEQKIRVS VEVEKPREEL FQLFGYGDVV FVSKDVAKHL GFQSAEEALR GLYGRVRKGA VLVCAWAEEG ADALGPDGKL LHSDAFPPPR VVDTLGAGDT FNASVIFSLS QGRSVQEALR FGCQVAGKKC GLQGFDGIV (1-298 aa encoded by BC006233 )
靶标信息
KHK encodes the gene ketohexokinase that catalyzes conversion of fructose to fructose-1-phosphate. The splice variant presented encodes the highly active form found in liver. renal cortex. and small intestine. while the alternate variant encodes the lowe
仅用于科研。不用于诊断过程。未经明确授权不得转售。
生物信息学
蛋白别名: fructokinase; Hepatic fructokinase; Ketohexokinase; KHK; testicular tissue protein Li 102
基因别名: FRUCTU; KETHPRO; KHK
UniProt ID: (Human) P50053, (Mouse) P97328, (Rat) Q02974
Entrez Gene ID: (Human) 3795, (Mouse) 16548, (Rat) 25659